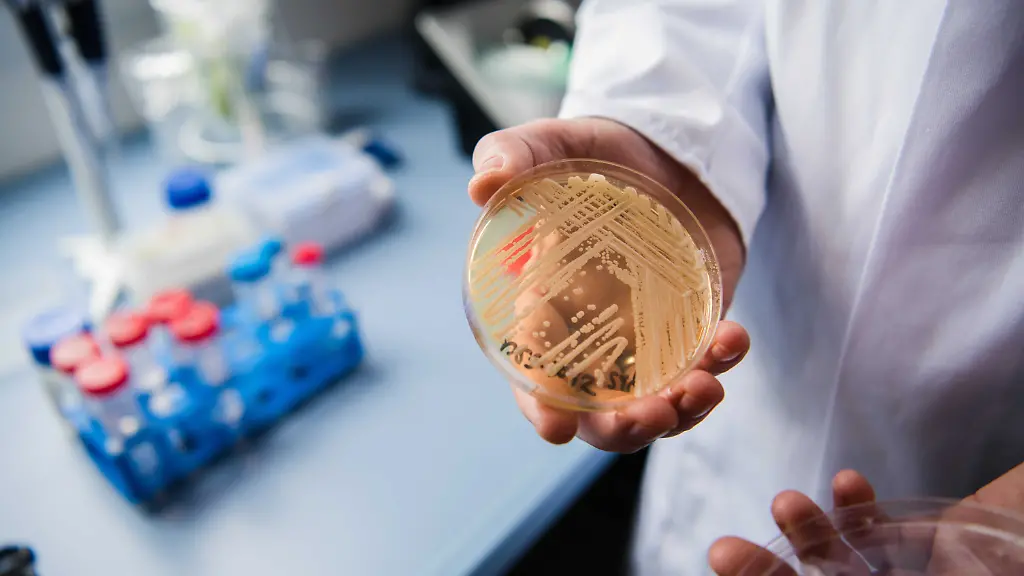
Der-Leiter-des-Nationalen-Referenzzentrums-fuer-invasive-Pilzinfektionen-Oliver-Kurzai-haelt-in-einem-Labor-der-Universitaet-in-Wuerzburg-Bayern-eine-Petrischale-mit-dem-Hefepilz-Candidozyma-auris-frueher-bekannt-als-Candida-auris-in-den-Haenden-In-Deutschland-werden-immer-mehr-Faelle-bekannt-in-denen-schwer-kranke-Patienten-mit-dem-gefaehrlichen-Hefepilz-Candidozyma-auris-frueher-bekannt-als-Candida-auris-infiziert-sind-zu-dpa-Experte-Neu-entdeckter-Hefepilz-ist-bedrohlich-aber-nicht-Ebola-vom-24-01

Ansteckung per SchmierinfektionEin tödlicher Pilz nistet sich in Europas Krankenhäusern ein
Von Caroline Amme
Candidozyma auris ist hochansteckend und überlebt sehr lange. Der Pilz ist in Europa angekommen und breitet sich inzwischen auch in deutschen Krankenhäusern aus. Gegen viele Anti-Pilz-Mittel ist er resistent. Ganz machtlos sind die Mediziner aber nicht.
Pilze kommen überall im und an unserem Körper vor. Das ist normal und nicht weiter schlimm. Nur wenige Pilzarten lösen bei Menschen Krankheiten aus, wie Hautpilze, Hefen und einige Schimmelpilze.
Seit einigen Jahren breitet sich weltweit ein Hefepilz rasant aus, der für einige Menschen lebensgefährlich sein kann: Candidozyma auris, früher bekannt als Candida auris. Entdeckt wurde er 2009 in Japan.
In europäischen Krankenhäusern tritt er immer öfter auf, heißt es in einem Bericht des Europäischen Zentrums für die Prävention und die Kontrolle von Krankheiten (ECDC). Zwischen 2013 und 2023 hat es demnach in der EU und im Europäischen Wirtschaftsraum rund 4000 Fälle gegeben. Deutschland liegt mit 120 Fällen auf Platz fünf - über die Hälfte davon sind allein 2023 beobachtet worden. Die meisten Fälle gab es in Spanien, Griechenland, Italien und Rumänien.
Dunkelziffer in Südeuropa hoch
In vielen Ländern gibt es - anders als in Deutschland - keine systematische Überwachung. So sei die Dunkelziffer beispielsweise in Spanien, Italien oder Griechenland sehr hoch, hat Oliver Kurzai, Leiter des Instituts für Hygiene und Mikrobiologie an der Julius-Maximilians-Universität Würzburg in einem Presse-Briefing gesagt. "In diesem Bericht sagen südeuropäische Länder, sie können nicht mehr unterscheiden, ob Candidozyma-auris-Fälle zu einem Ausbruch gehören oder normal da sind." Für Deutschland sei das alarmierend, denn: "Wenn Urlauber in Südeuropa mit dem Krankenhaussystem in Kontakt kommen, besteht ein Risiko, dass dieser Erreger vermehrt zu uns eingetragen wird."
Was diesen Pilz so tückisch macht, ist: Im Gegensatz zu ähnlichen Erregern ist er sehr ansteckend. Und er ist von Mensch zu Mensch übertragbar. "Die Übertragung ist eine sogenannte Schmierinfektion. Das heißt, meistens indirekt von einem Patienten, der besiedelt oder infiziert ist, auf einen weiteren Patienten - eventuell auch transient über zum Beispiel Pflegepersonal oder Ärzte", erläutert Kurzai. Deshalb breitet er sich in Krankenhäusern auch so schnell aus.
Über die Luft wie Corona-Viren wird Candidozyma auris nicht übertragen. Aber er überlebt lange auf verschiedenen Oberflächen und lässt sich davon nur schwer entfernen. Mithilfe von Biofilmen schütze er sich vor dem Immunsystem und vor den Medikamenten, erläutert Kurzai.
Das gilt auch für medizinische Geräte oder Instrumente. "Der wichtigste Übertragungsweg sind Geräte, die schlecht desinfizierbar sind, die an mehreren Patienten eingesetzt werden", sagt Kurzai - wie Temperatursonden oder Spatel für die Lungenspiegelung. Auch auf Prothesen könne er sich ansiedeln.
Candidozyma auris kann Blutvergiftung auslösen
Der Hefepilz siedelt sich zum Beispiel auf der Haut an. Das allein macht noch nicht krank. Für gesunde Menschen ist eine Infektion meist ungefährlich. Sie merken oft gar nicht, dass sie sich angesteckt haben, sagt Kurzai.
Zum Problem wird der Pilz erst dann, wenn das Immunsystem zu schwach ist, um ihn zu kontrollieren. Dann kann er sich im Körper ausbreiten, in die Blutbahn kommen und dort eine Blutvergiftung verursachen. Für fast jeden zweiten Patienten ist das tödlich. In Deutschland sind bisher keine Todesfälle durch eine Infektion mit dem Pilz bekannt.
Gefährdet sind Menschen mit einem schwachen Abwehrsystem: frisch Operierte, Ältere, Frühgeborene sowie kranke Menschen. "Das sind immungeschwächte Patienten, die eine Krebserkrankung haben, die frisch operiert sind, die chronisch krank sind, zum Beispiel eine Nierendialyse benötigen", sagt Georg-Christian Zinn, Direktor des Hygienezentrums Bioscientia, bei RTL.
Händehygiene entscheidend
Eine Infektion mit Candidozyma auris kann für hohes Fieber sorgen, für Schüttelfrost oder Wundinfektionen. Umso wichtiger ist es, zu verhindern, dass sich der Hefepilz ausbreitet. Infizierte sollten rechtzeitig isoliert werden.
Entscheidend im Krankenhaus ist die Hygiene. Tim Eckmanns vom Robert-Koch-Institut (RKI) macht klar: Für die Infektionsprävention und -kontrolle sei die Händehygiene mit am wichtigsten, weil der Erreger häufig durch medizinisches Personal übertragen werde.
Doch nicht alle Desinfektionsmittel wirken gegen Candidozyma auris. Für die Handdesinfektion werden alkoholische Desinfektionsmittel empfohlen, für die Flächendesinfektion ein chlorhaltiges Mittel. "Es gibt Berichte aus Großbritannien, wo die Patienten mit Chlorhexidin-Waschungen versorgt wurden, um die Ausbreitung zu verhindern, und das hat nicht wirklich gut gewirkt", sagt Birgit Willinger, Leiterin der Klinischen Abteilung für Klinische Mikrobiologie an der Medizinischen Universität Wien. Die Desinfektionsmittel in deutschen Krankenhäusern seien aber gut wirksam, sagt Kurzai.
"Niemand muss sich Sorgen machen"
Einmal angesteckt, kann der Pilz nicht immer behandelt werden. Denn er ist auch gegen viele herkömmliche Anti-Pilz-Mittel resistent. In den USA und in Indien gebe es Stämme, gegen die gar kein Antimykotikum mehr hilft, weiß Kurzai. Je häufiger der Erreger, desto resistenter werde er auch.
In Deutschland seien die meisten Candidozyma-auris-Stämme gut behandelbar, macht der Experte für Pilzinfektionen deutlich. Nur einige wenige hätten eine Resistenz gegen bestimmte Anti-Pilz-Medikamente entwickelt. Neue Antimykotika seien in der klinischen Entwicklung. "Stand heute muss sich niemand Sorgen machen, dass wir hier mit einem Erreger konfrontiert sind, für den wir überhaupt keine Behandlungsoptionen mehr haben."
Noch sei der Pilz in Deutschland eine "Rarität", sagt Kurzai. Mit ihm in Kontakt zu kommen, sei wenig wahrscheinlich. Damit sich das nicht ändert, wird gerade darüber diskutiert, die Meldepflicht auszuweiten. Momentan muss der Erreger in Deutschland zwar gemeldet werden, aber nur dann, wenn er auch eine Infektion verursacht.
Experte zu Pandemiegefahr
Ansteckend ist Candidozyma auris aber schon viel früher. Schon dann, wenn ihn jemand am Körper hat, ohne Symptome zu haben. Man kann ihn monate-, teils sogar jahrelang, mit sich herumtragen - auch infolge einer Infektion. In dieser Zeit kann man unzählige andere Menschen anstecken. Eckmanns berichtet von Kontaktpatienten, die erst "nach drei, vier, fünf Wochen" positiv waren. Die lange Isolationszeit stelle Kliniken "vor logistische Herausforderungen".
Wenn man jedem einzelnen Fall nachgeht, würde sich der Pilz zwar immer noch ausbreiten - aber langsamer, glaubt der Experte vom RKI. Mit einer weltweiten Pandemie wie bei Covid-19 rechnet er aber nicht.
Wie schnell sich Candidozyma auris über Krankenhausnetzwerke ausbreitet, sieht man in Griechenland, Italien und Spanien. Innerhalb von nur fünf bis sieben Jahren ist der Pilz dort heimisch geworden, steht in dem ECDC-Bericht. Ausrotten kann man ihn nicht. Aber man kann ihn in den Griff bekommen: indem man den Erreger früh erkennt, überwacht und Hygieneregeln einhält.